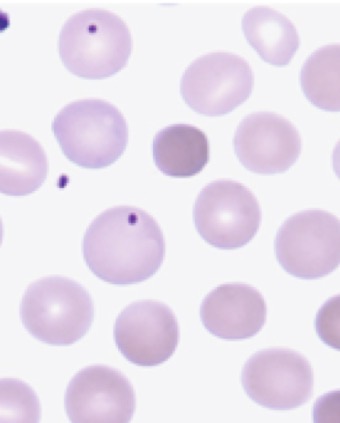
term image
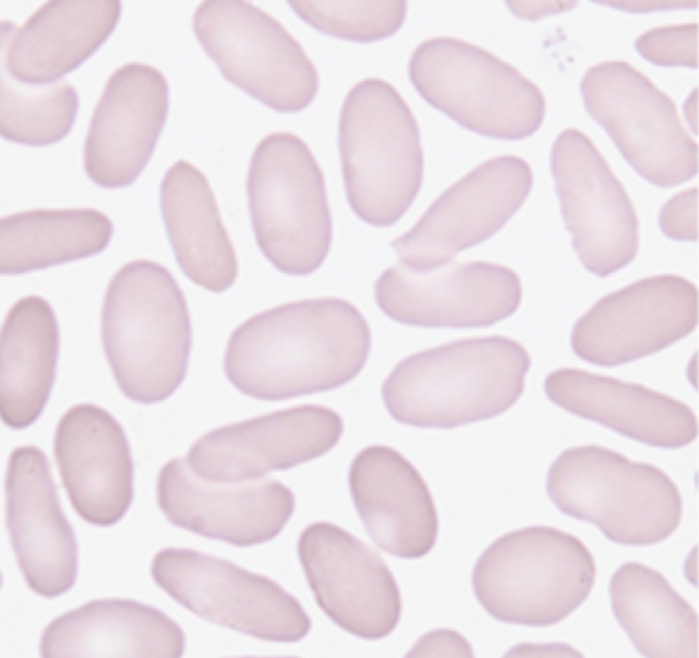
term image
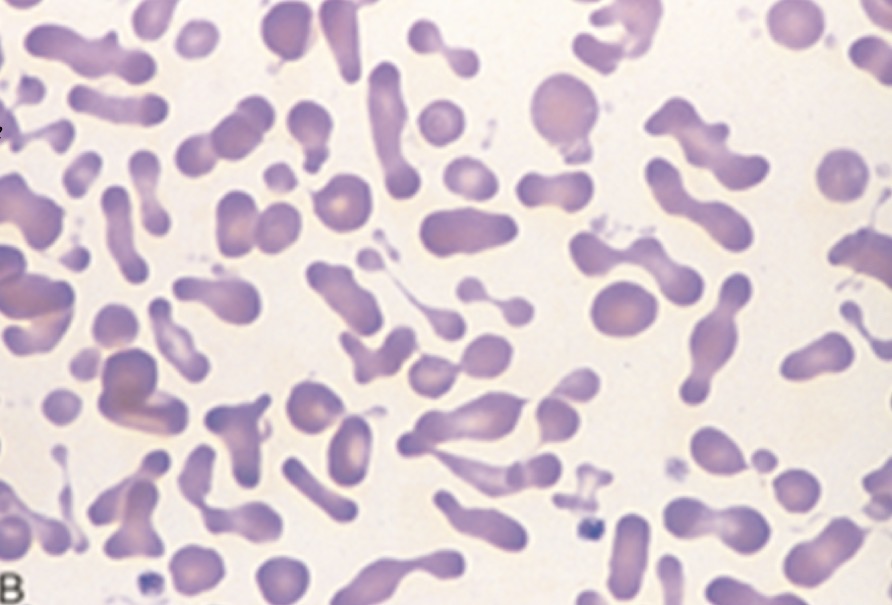
term image
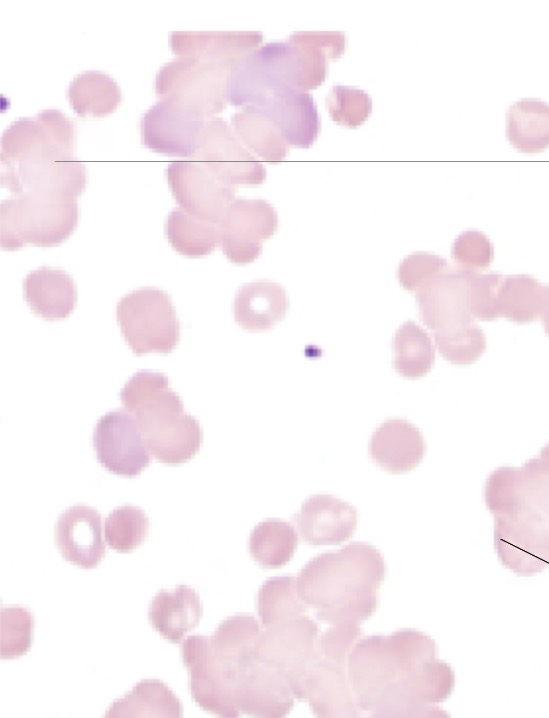
knowt flashcard image
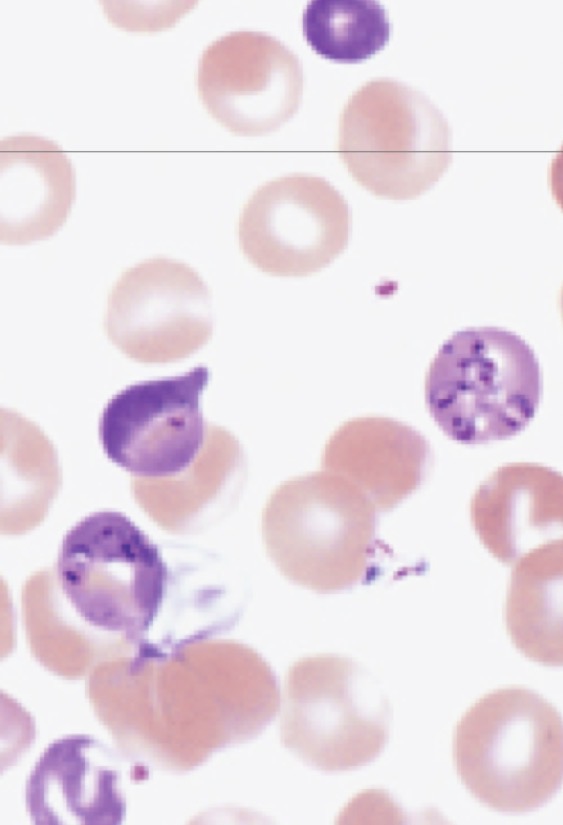
knowt flashcard image

MLS advanced heme exam 1
1/55
There's no tags or description
Looks like no tags are added yet.
Name | Mastery | Learn | Test | Matching | Spaced | Call with Kai |
|---|
No analytics yet
Send a link to your students to track their progress
56 Terms
Describe the structure of the red cell membrane
Lipids bilayer composed of phospholipids and cholesterol. Peripheral proteins in the cytoplasm like spectrin and ankyrin. Integral proteins are incorporated into phospholipid bilayer. Over 300 antigen structures
State the functions of spectrin
Provides structural support, long, flexible protein forming a mesh-like network
State the functions of ankyrin
Anchors spectrin to the membrane, maintains membrane stability
Describe difference in metabolism between a reticulocyte and a mature red cell
Reticulocytes are metabolically active, have aerobic and anaerobic metabolism, protein synthesis and more efficient energy production while mature RBC are minimalist survival cells with only anaerobic metabolism and no protein synthesis.
State the major energy source of mature RBCs
Glucose
List the erythrocyte metabolic processes that require energy
State the major metabolic pathway by which the mature red cell generates its energy
Embden Meyerhoff anaerobic pathway produces 90% of ATP in RBCs
Three ancillary pathways associated with the major metabolic pathway and purpose of each
Hexose monophosphate (HMP) shunt → produce glutathione 2. Methemoglobin reductase pathway → maintain Fe2+ form of iron in heme 3. Rapoport-Luebering Pathway→ produce 2,3-BPG
Explain the importance of G6PD in the formation of Heinz bodies
G6PD is a key enzyme in HMP shunt so when deficient, hemoglobin becomes oxidized and denatured hemoglobin precipitates leading to Heinz bodies. These will damage the membrane and lead to hemolysis
Hemolysis definition
Destruction of red blood cells leading to release of hemoglobin into plasma or macrophages
The major site of normal red cell breakdown
Primarily occurs in the spleen
Describe the pathway of heme degredation
Hemoglobin split into globin chains and heme→ iron (reused/stored) and protoporphyrin → bilirubin
Site of intra and extravascular hemolysis
Intra: inside blood vessels, extra: macrophages in the spleen, liver or bone marrow
Describe the processes of intravascular and extravascular hemolysis, including site of hemolysis, catabolic products, and relative timeframe for the appearance of those products after hemolysis.
Describe the fate of the different components of hemoglobin as red cells are broken down by macrophages (extravascular hemolysis).
Globin is broken into amino acids and reused, iron is stored a ferritin/hemosiderin and transported via transferrin and heme (protoporphyrin)→biliverdin→ unconjugated bilirubin→travels to liver
Describe the fate of hemoglobin following hemolysis
Binds haptoglobin
Match the plasma proteins to the RBC degradation product that binds to the proteins
Haptoglobin binds free hemoglobin, hemopexin binds free heme, albumin binds unconjugated bilirubin and methemoglobin, transferring binds iron (Fe3+→2+)
Increased rate of RBCs destruction which leads to a shortened RBC lifespan
Definition of hemolysis
Definition of hemolytic anemia
Rate of RBC destruction exceeds RBC production
Two general categories of hemolytic anemia
Intra and extravascular hemolysis
State the site of hemolysis in intravascular hemolysis forms and describe the fate of hemoglobin
Within blood vessels, free hemoglobin is released into circulation→ binds to haptoglobin forming hb-hp complex→ removed by macrophages in liver and spleen. When haptoglobin gets used up in severe hemolysis → hemoglobinemia
State the site of hemolysis in extravascular hemolysis forms and describe the fate of hemoglobin in each instance
In spleen or liver, macrophage engulfs RBC and breaks down hemoglobin→ iron and protoporphyrin, →iron stored and protoporhyrin →biliverdin→ unconjugated bilirubin→ urobilinogen excreted in stool
General PBSM features of hemolytic anemia
Reticulocytosis (increased immature RBCs), anisocytosis, poikilocytosis, possible nucleated RBCs
What hemolytic anemias will you see spherocytes in?
Hereditary spherocytosis, immune hemolytic anemia (IgG), thermal injury
What hemolytic anemias will you see elliptocytes/ovalocytes in?
Hereditary elliptocytosis aka southeast asian elliptocytosis
What hemolytic anemias will you see acanthocytes in?
Severe liver disease
What hemolytic anemias will you see Burr cells in?
Pyruvate kinase (PK) deficiency, uremia
What hemolytic anemias will you see schistocytes in?
Immune hemolytic anemia (IgM- larger and immediate fragmentation of RBC, binds complement), cardiac trauma, microangiopathic hemolytic anemia- fragmentation hemolysis
What hemolytic anemias will you see RBC Agglutination in?
Cold agglutinin diseases, immune hemolytic diseases
What hemolytic anemias will you see erythrophagocytosis in?
Damage to RBC surface by complement-fixing antibodies
Can you see erythrophagocytosis on PBSMs?
Not seen as morphology on PBSM, seen in severe case of complement…
Etiology and PBSM of hereditary spherocytosis
Ankyrin mutation (ANK1 most frequently) causing instability→ vesicles form and split off RBC→ membrane loss, decreased S:V ratio→ spherocytes. Extravascular hemolysis (get stuck in spleen). PBSM: spherocytes, HJ bodies in moderate-severe, increased osmotic fragility
Laboratory findings of hereditary spherocytosis
Deecreased HGB, increased MCHC(greater than 36g/dL, analyzer flag), retics, spherocytes and polychromasia. Negative DAT, decreased haptoglobin, increased LDH and indirect biliruben, increased osmotic fragility test
What to associate osmotic fragility test with?
Hereditary spherocytosis or thalassemia

Hereditary spherocytosis
Etiology and lab findings of hereditary elliptocytosis
Spectrin mutation (SPTA or SPTb), most patients are asymptomatic, 10% are moderate-severe, elliptical shaped RBC
Hereditary elliptocytosis
Etiology and laboratory feature of hereditary pyropoikilocytosis
Marked thermal sensitivity- morphology changes after 1 hr incubation, now considered a severe form of HE (spectrin mutation), severe anemia with poikilocytosis, bizarre shapes and forms, decreased MCV 50-65, PBSM: fragments, microspherocytes, elliptocytes
Hereditary pyropoikilocytosis
Describe the mechanisms of spherocyte formation in immune hemolytic anemia
IgG binds to RBC, targeting for removal. Splenic macrophages partially phagocytose the membrane causing a loss of membrane surface area, while volume stays the same→ spherocyte
Whats a lab procedure used to differentiate immune spherocytosis from hereditary spherocytosis
DAT (Direct Antiglobulin test) aka Coombs test. Immune: positive, hereditary: negative
State the mechanism of hemolysis in oxidant hemoytic states
Ex. G6PD enzyme deficiency→ oxidative damage→ Heinz bodies→ splenic macrophages remove these damaged portions leading to extravascular hemolysis
Describe the typical blood smear morphology in the G6PD
Heinz bodies (on supravital stain), positive auto hemolysis
List and explain factors which lead to acquired extrinsic types of hemolysis
Immune mediated destruction- antibodies bind to RBC leading to hemolysis, infections- pathogens can invade RBC causing destruction, mechanical (traumatic) damage- physical force shears RBC in circulation, chemical or drug induced, hypersplenism- enlarged spleen, thermal injury
Explain the principle and significance of the osmotic fragility test
Read on a spectophotometer, starts out at with a titration of sodium chloride and an isotonic amount of water, then it increases in hypotonic solution. It tells apart thalassemia and hereditary spherocytosis.
Explain the red cell abnormality and mechanism of cell destruction in paroxysmal nocturnal hemoglobinuria (PNH)
Caused by HSC mutations that result in lack of GPI-anchored proteins, such as CD55 and CD59(prevent compliment activation), causes chronic intravascular hemolytic anemia
Explain the principles of laboratory tests used to identify PNH
Flow cytometry- absence of CD55 and CD59(both needed to have complement and lysis so w/o causes chronic hemolysis, also hemoglobinemia, hemoglobinuria, decreased serum haptoglobin, increased unconjuated bilirubin and LDH, hemosiderinuria, elevated retics
Compare and contrast cold and warm types of immune hemolytic anemias
Both autoimmune. Warm: autoantibodies react at body temperature (37 C), primarily IgG, DAT positive, symptoms of anemia and can be life threatening. Cold: IgM antibodies cold reacting (4C) and activates complement. Can be secondary to viral infections, walking pneumonia and mono. Mild anemia
Describe the typical blood smear morphology seen in the warm hemolytic anemia
Mainly Spherocytes, polychromasia but also anisocytosis and poikilocytosis
Describe the typical blood smear morphology seen in the cold types of hemolytic anemia
List the parasites that can be found in blood
Malaria- p. Falciparum, vivax, ovale, malariae, knowlesi. Babeiosis- babesia microti tickborne disease
Morphology of Plasmodium spp.

Morphology of babesia spp.
Aplastic anemia causes
80-85% are acquired, 15-20% inherited: Fanconi anemia, Dyskeratosis congenital, Schwachman-Bodian-Diamond syndrome
Aplastic anemia overview
Rare but potentially fatal bone marrow failure syndrome
Aplastic anemia characteristics and lab findings
Pancytopenia, bone marrow hypocellularity, depletion of HSC, ANC decreased, Hgb <10g/dL, MCV increased to normal, retics decreased, bone marrrow sh